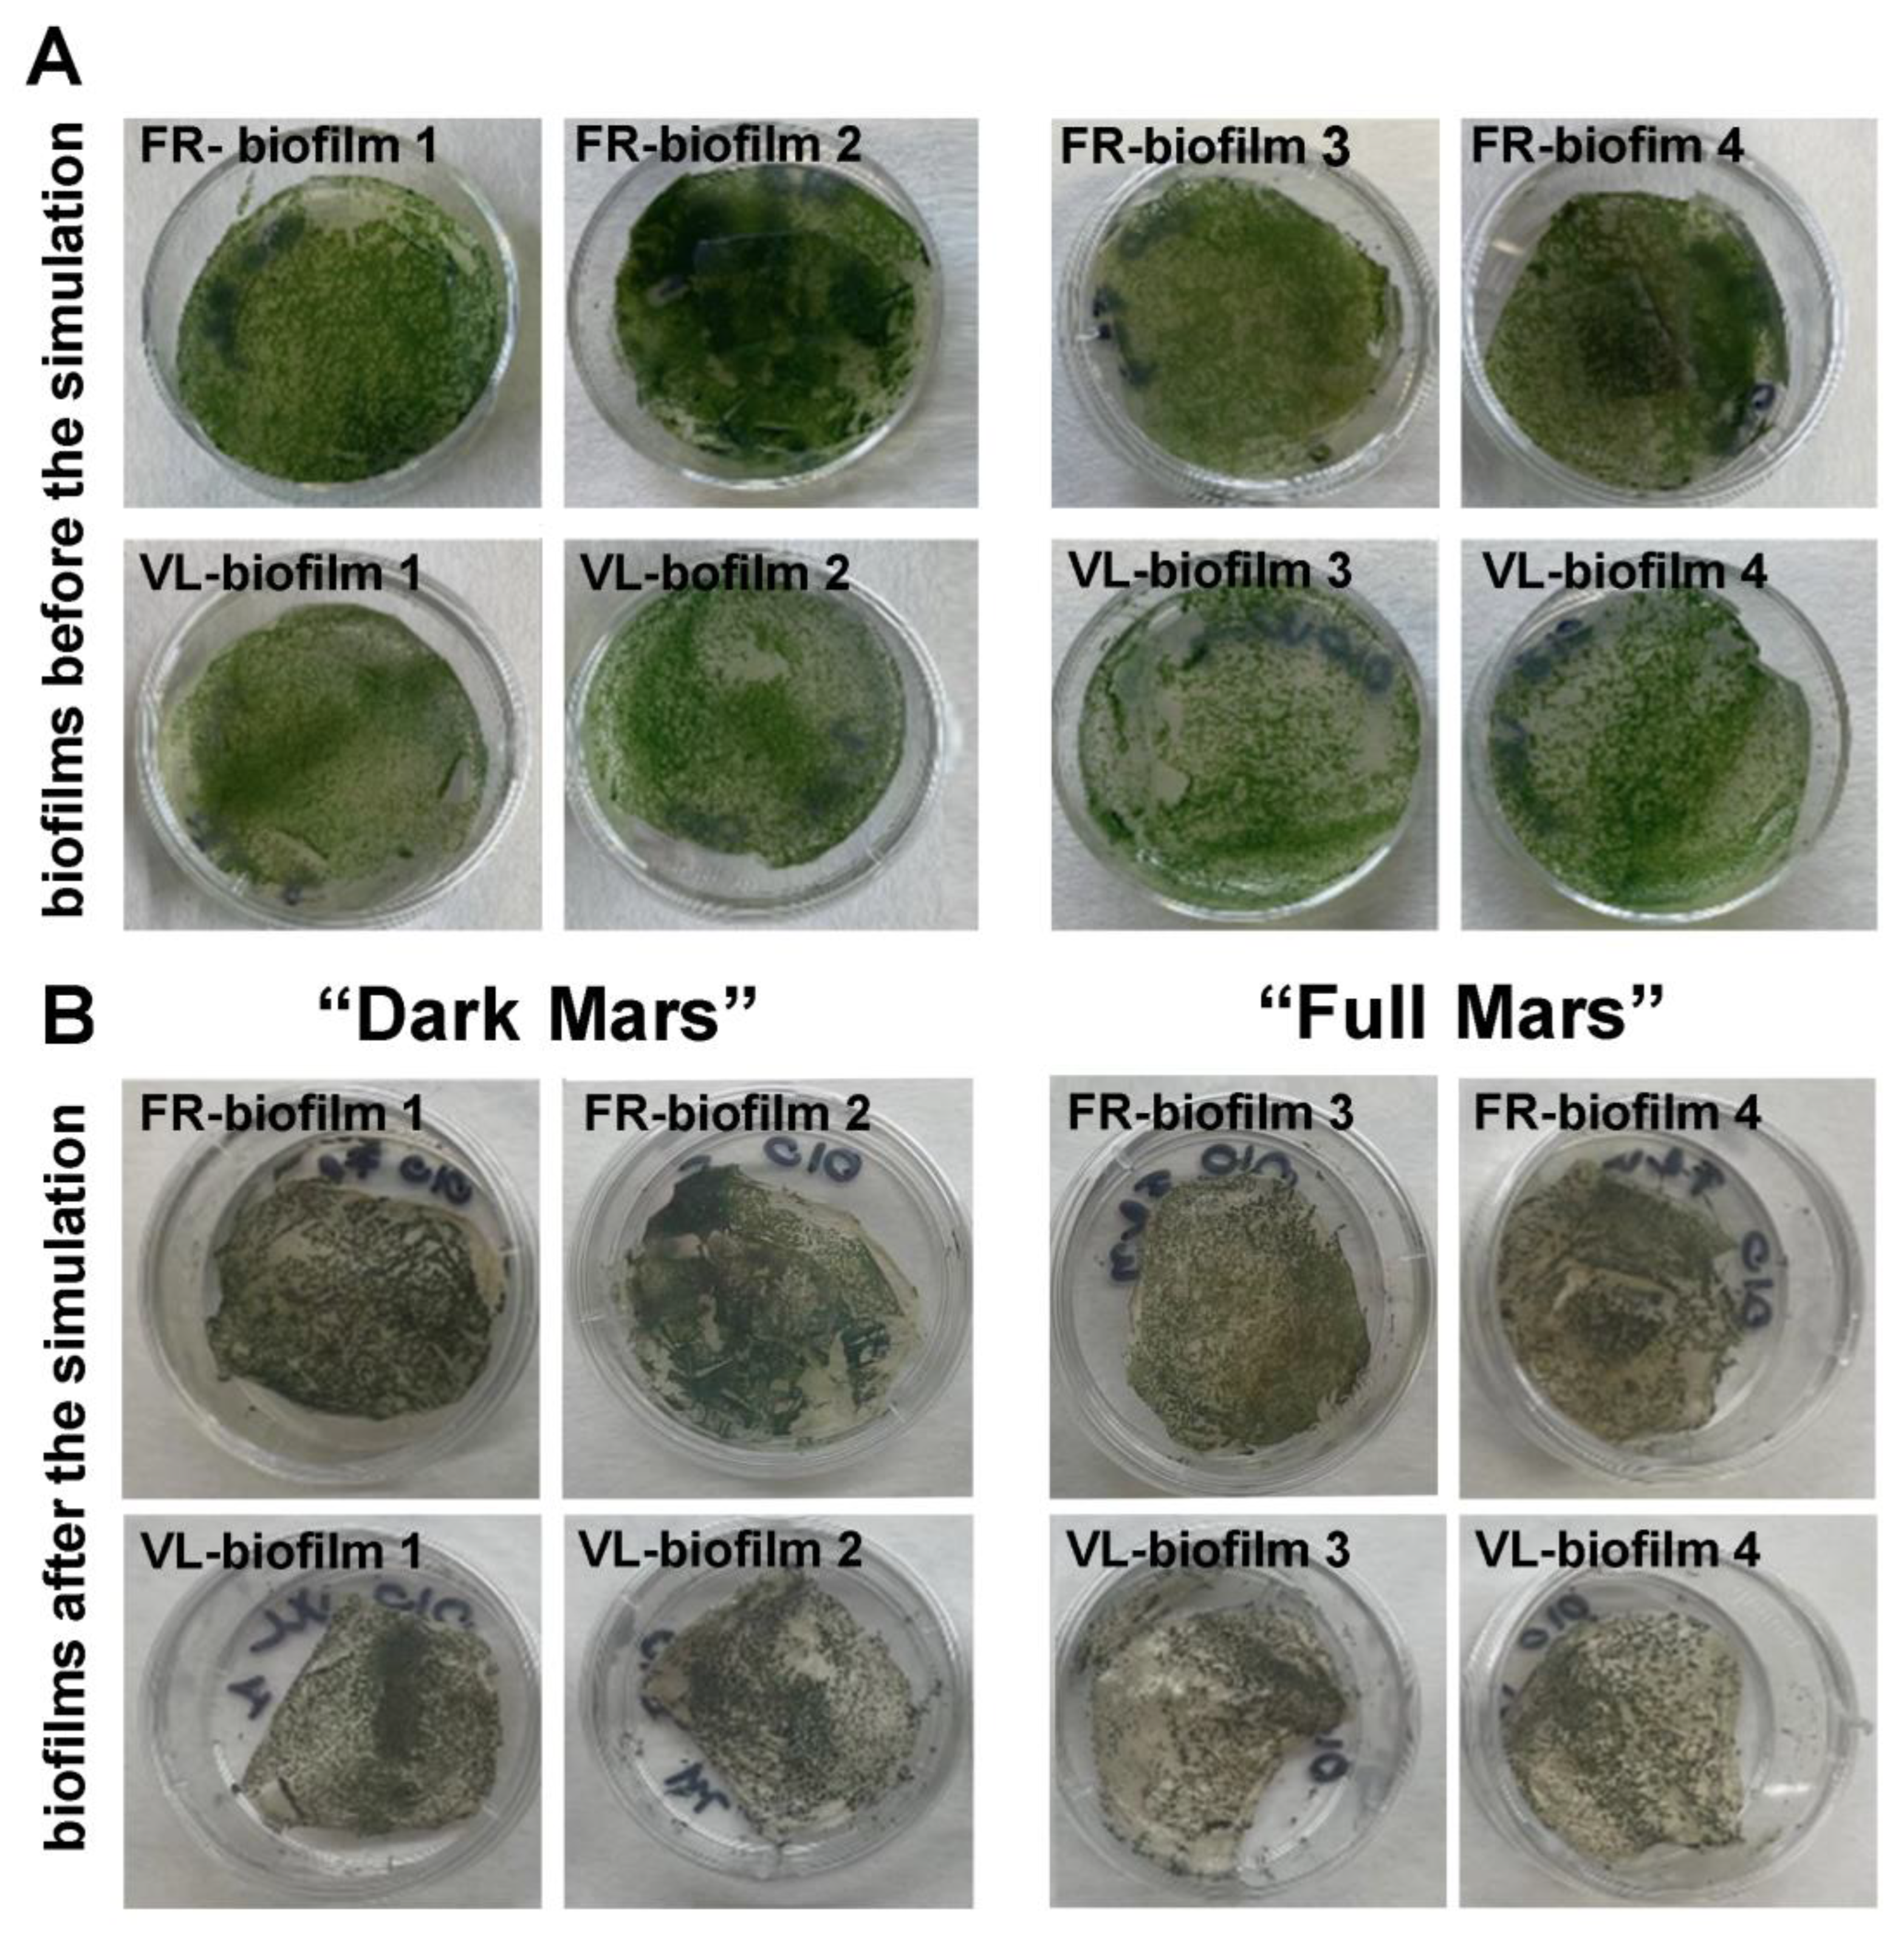
Life 15 00622 g004

Resilience of Metabolically Active Biofilms of a Desert Cyanobacterium Capable of Far-Red Photosynthesis Under Mars-like Conditions
Abstract
1. Introduction
2. Materials and Methods
2.1. Cyanobacterial Strain, Growth Conditions, and Biofilm Development
2.2. Mars Simulation Chamber
2.3. Biofilm Integration in the Mars Simulation Chamber
2.4. Photosynthetic Activity Measurement
2.5. Photosynthetic Pigment Autofluorescence
2.6. Cell Viability
3. Results
3.1. Experimental Mars-like Conditions
3.2. Photosynthetic Activity in Biofilms During Mars Simulation
3.3. Visual Inspection of Biofilms Exposed to Mars Simulation
3.4. Photosynthetic Pigments in Biofilms Exposed to Mars Simulation
3.5. Cell Viability of Biofilms Exposed to Mars Simulation
4. Discussion
5. Conclusions
Author Contributions
Funding
Informed Consent Statement
Data Availability Statement
Acknowledgments
Conflicts of Interest
References
- Kite, E.S.; Conway, S. Geological evidence for multiple climate transitions on Early Mars. Nat. Geosci. 2024, 17, 10–19. [Google Scholar] [CrossRef]
- Carter, J.; Loizeau, D.; Mangold, N.; Poulet, F.; Bibring, J.P. Widespread surface weathering on early Mars: A case for a warmer and wetter climate. Icarus 2015, 248, 373–382. [Google Scholar] [CrossRef]
- McKay, C.P. The search for life on Mars. Orig. Life Evol. Biosph. 1997, 27, 263–289. [Google Scholar] [CrossRef] [PubMed]
- Cockell, C.S.; Catling, D.C.; Davis, W.L.; Snook, K.; Kepner, R.L.; Lee, P.; McKay, C.P. The ultraviolet environment of Mars: Biological implications past, present, and future. Icarus 2000, 146, 343–359. [Google Scholar] [CrossRef] [PubMed]
- Patel, M.R.; Bérces, A.; Kerékgyárto, T.; Rontó, G.; Lammer, H.; Zarnecki, J.C. Annual solar UV exposure and biological effective dose rates on the martian surface. Adv. Space Res. 2004, 33, 1247–1252. [Google Scholar] [CrossRef]
- Wray, J.J. Contemporary liquid water on Mars? Annu. Rev. Earth Planet. Sci. 2021, 49, 141–171. [Google Scholar] [CrossRef]
- Davila, A.F.; Schulze-Makuch, D. The last possible outposts for life on Mars. Astrobiology 2016, 16, 159–168. [Google Scholar] [CrossRef]
- Cockell, C.S.; Raven, J.A. Zones of photosynthetic potential on Mars and the early Earth. Icarus 2004, 169, 300–310. [Google Scholar] [CrossRef]
- Westall, F.; Loizeau, D.; Foucher, F.; Bost, N.; Bertrand, M.; Vago, J.; Kminek, G. Habitability on Mars from a microbial point of view. Astrobiology 2013, 13, 887–897. [Google Scholar] [CrossRef]
- Behrendt, L.; Brejnrod, A.; Schliep, M.; Sørensen, S.J.; Larkum, A.W.D.; Kühl, M. Chlorophyll f-driven photosynthesis in a cavernous cyanobacterium. ISME J. 2015, 9, 2108–2111. [Google Scholar] [CrossRef]
- Gan, F.; Shen, G.; Bryant, D.A. Occurrence of far-red light photoacclimation (FaRLiP) in diverse cyanobacteria. Life 2015, 5, 4–24. [Google Scholar] [CrossRef]
- Kurashov, V.; Ho, M.Y.; Shen, G.; Piedl, K.; Laremore, T.N.; Bryant, D.A.; Golbeck, J.H. Energy transfer from chlorophyll f to the trapping center in naturally occurring and engineered photosystem I complexes. Photosynth. Res. 2019, 141, 151–163. [Google Scholar] [PubMed]
- Lehmer, O.R.; Catling, D.C.; Parenteau, M.N.; Kiang, N.Y.; Hoehler, T.M. The peak absorbance wavelength of photosynthetic pigments around other stars from spectral optimization. Front. Astron. Space Sci. 2021, 8, 689441. [Google Scholar]
- Battistuzzi, M.; Cocola, L.; Claudi, R.; Pozzer, A.C.; Segalla, A.; Simionato, D.; Morosinotto, T.; Poletto, L.; La Rocca, N. Oxygenic photosynthetic responses of cyanobacteria exposed under an M-dwarf starlight simulator: Implications for exoplanet’s habitability. Front. Plant Sci. 2023, 14, 1070359. [Google Scholar]
- Battistuzzi, M.; Cocola, L.; Liistro, E.; Claudi, R.; Poletto, L.; La Rocca, N. Growth and photosynthetic efficiency of microalgae and plants with different levels of complexity exposed to a simulated M-dwarf dtarlight. Life 2023, 13, 1641. [Google Scholar] [PubMed]
- Schwieterman, E.W.; Kiang, N.Y.; Parenteau, M.N.; Harman, C.E.; DasSarma, S.; Fisher, T.M.; Arney, G.N.; Hartnett, H.E.; Reinhard, C.T.; Olson, S.L.; et al. Exoplanet biosignatures: A review of remotely detectable signs of life. Astrobiology 2018, 18, 663–708. [Google Scholar] [PubMed]
- Martins, Z.; Cottin, H.; Kotler, J.M.; Carrasco, N.; Cockell, C.S.; de la Torre Noetzel, R.; Demets, R.; de Vera, J.P.; d’Hendecourt, L.; Ehrenfreund, P.; et al. Earth as a tool for astrobiology—A European perspective. Space Sci. Rev. 2017, 209, 43–81. [Google Scholar] [CrossRef]
- Antonaru, L.; Selinger, V.M.; Jung, P.; Di Stefano, G.; Sanderson, N.D.; Barker, L.; Wilson, D.J.; Büdek, B.; Canniffe, D.P.; Billi, D.; et al. Common loss of far-red light photoacclimation in cyanobacteria from hot and cold deserts: A case study in the Chroococcidiopsidales. ISME Commun. 2023, 3, 113. [Google Scholar]
- Meslier, V.; Casero, M.C.; Dailey, M.; Wierzchos, J.; Ascaso, C.; Artieda, O.; McCullough, P.R.; Di Ruggiero, J. Fundamental drivers for endolithic microbial community assemblies in the hyperarid Atacama Desert. Environ. Microbiol. 2018, 20, 1765–1781. [Google Scholar] [PubMed]
- Smith, H.D.; Baqué, M.; Duncan, A.G.; Lloyd, C.R.; McKay, C.P.; Billi, D. Comparative analysis of cyanobacteria inhabiting rocks with different light transmittance in the Mojave Desert: A Mars terrestrial analogue. Int. J. Astrobiol. 2014, 13, 271–277. [Google Scholar]
- Rabbow, E.; Rettberg, P.; Parpart, A.; Panitz, C.; Schulte, W.; Molter, F.; Jaramillo, R.; Demets, R.; Weiß, P.; Wilnecker, R. EXPOSE-R2: The astrobiological ESA mission on board of the International Space Station. Front. Microbiol. 2017, 8, 1533. [Google Scholar] [CrossRef]
- Billi, D.; Verseux, C.; Fagliarone, C.; Napoli, A.; Baqué, M.; de Vera, J.P. A desert cyanobacterium under simulated Mars-like conditions in low earth orbit: Implications for the habitability of Mars. Astrobiology 2019, 19, 158–169. [Google Scholar] [CrossRef] [PubMed]
- Billi, D.; Staibano, C.; Verseux, C.; Fagliarone, C.; Mosca, C.; Baqué, M.; Rabbow, E.; Rettberg, P. Dried biofilms of desert strains of Chroococcidiopsis survived prolonged exposure to space and Mars-like conditions in low earth orbit. Astrobiology 2019, 19, 1008–1017. [Google Scholar] [PubMed]
- Billi, D.; Napoli, A.; Mosca, C.; Fagliarone, C.; De Carolis, R.; Balbi, A.; Scanu, M.; Selinger, V.M.; Antonaru, L.A.; Nürnberg, D.J. Identification of far-red light acclimation in an endolithic Chroococcidiopsis strain and associated genomic features: Implications for oxygenic photosynthesis on exoplanets. Front. Microbiol. 2022, 13, 933404. [Google Scholar] [CrossRef]
- Lorek, A.; Koncz, A. Simulation and measurement of extraterrestrial conditions for experiments on habitability with respect to Mars. In Habitability of Other Planets and Satellites Cellular Origin, Life in Extreme Habitats and Astrobiology; de Vera, J.P., Seckbach, J., Eds.; Springer: Dordrecht, The Netherlands, 2013; pp. 145–162. [Google Scholar]
- de la Torre Noetzel, R.; Miller, A.Z.; de la Rosa, J.M.; Pacelli, C.; Onofri, S.; García Sancho, L.; Cubero, B.; Lorek, A.; Wolter, D.; de Vera, J.P. Cellular responses of the lichen Circinaria gyrosa in Mars-like conditions. Front. Microbiol. 2018, 9, 308. [Google Scholar]
- Lorenz, C.; Bianchi, E.; Poggiali, G.; Alemanno, G.; Benesperi, R.; Brucato, J.R.; Garland, S.; Helbert, J.; Loppi, S.; Lorek, A.; et al. Survivability of the lichen Xanthoria parietina in simulated Martian environmental conditions. Sci. Rep. 2023, 13, 4893. [Google Scholar] [CrossRef]
- Baker, N.R. Chlorophyll fluorescence: A probe of photosynthesis in vivo. Annu. Rev. Plant Biol. 2008, 59, 89–113. [Google Scholar]
- Mullineaux, C.W.; Mariscal, V.; Nenninger, A.; Khanum, H.; Herrero, A.; Flores, E.; Adams, D.G. Mechanism of intercellular molecular exchange in heterocyst-forming cyanobacteria. EMBO J. 2008, 27, 1299–1308. [Google Scholar] [CrossRef] [PubMed]
- Flemming, H.C.; Wingender, J.; Szewzyk, U.; Steinberg, P.; Rice, S.A.; Kjelleberg, S. Biofilms: An emergent form of bacterial life. Nat. Rev. Microbiol. 2016, 14, 563–575. [Google Scholar]
- Cockell, C.S.; Schuerger, A.C.; Billi, D.; Friedmann, E.I.; Panitz, C. Effects of a simulated martian UV flux on the cyanobacterium, Chroococcidiopsis sp. 029. Astrobiology 2005, 5, 127–140. [Google Scholar] [CrossRef]
- Baqué, M.; Viaggiu, E.; Scalzi, G.; Billi, D. Endurance of the endolithic desert cyanobacterium Chroococcidiopsis under UVC radiation. Extremophiles 2013, 17, 161–169. [Google Scholar] [PubMed]
- Ho, M.Y.; Shen, G.; Canniffe, D.P.; Zhao, C.; Bryant, D.A. Light-dependent chlorophyll f synthase is a highly divergent paralog of PsbA of photosystem II. Science 2016, 353, aaf9178. [Google Scholar] [CrossRef] [PubMed]
- de Vera, J.P.; Schulze-Makuch, D.; Khan, A.; Lorek, A.; Koncz, A.; Möhlmann, D.; Spohn, T. Adaptation of an antarctic lichen to martian niche conditions can occur within 34 days. Planet. Space Sci. 2014, 98, 182–190. [Google Scholar] [CrossRef]
- Verseux, C. Bacterial growth at low pressure: A short review. Front. Astron. Space Sci. 2020, 7, 30. [Google Scholar] [CrossRef]
- Verseux, C.; Heinicke, C.; Ramalho, T.P.; Determann, J.; Duckhorn, M.; Smagin, M.; Avila, M. A low-pressure, N2/CO2 atmosphere is suitable for cyanobacterium-based life-support systems on Mars. Front. Microbiol. 2021, 12, 611798. [Google Scholar] [CrossRef]
- Krämer, C.E.M.; Singh, A.; Helfrich, S.; Grünberger, A.; Wiechert, W.; Nöh, K.; Kohlheyer, D. Non-invasive microbial metabolic activity sensing at single cell level by perfusion of calcein acetoxymethyl ester. PLoS ONE 2015, 10, e0141768. [Google Scholar] [CrossRef]
- Nicholson, W.L. Ancient micronauts: Interplanetary transport of microbes by cosmic impacts. Trends Microbiol. 2009, 17, 243–250. [Google Scholar] [CrossRef]
- Cockell, C.; Raven, J.A. Ozone and life on the Archaean Earth. Philos. Trans. A Math. Phys. Eng. Sci. 2007, 365, 1889–1901. [Google Scholar]

| Experimental Parameters | “Full Mars” | “Dark Mars” |
|---|---|---|
| Atmosphere | 95% CO2, 4% N2, 1% O2 | 95% CO2, 4% N2, 1% O2 |
| Pressure | 600 Pa | 600 Pa |
| PAR (400–700 nm) | 3 W/m2 | / |
| UV (200–400 nm) | 14 W/m2 | / |
| Humidity | 0% (day) | 0% |
| 75% (night) | 75% (night) | |
| Temperature | +15 °C (day 16 h) | +15 °C (day 16 h) |
| −50 °C (night 8 h) | −50 °C (night 8 h) |
Disclaimer/Publisher’s Note: The statements, opinions and data contained in all publications are solely those of the individual author(s) and contributor(s) and not of MDPI and/or the editor(s). MDPI and/or the editor(s) disclaim responsibility for any injury to people or property resulting from any ideas, methods, instructions or products referred to in the content. |
© 2025 by the authors. Licensee MDPI, Basel, Switzerland. This article is an open access article distributed under the terms and conditions of the Creative Commons Attribution (CC BY) license (https://creativecommons.org/licenses/by/4.0/).
Share and Cite
Di Stefano, G.; Baqué, M.; Garland, S.; Lorek, A.; de Vera, J.-P.; Gangi, M.E.M.; Bellucci, M.; Billi, D. Resilience of Metabolically Active Biofilms of a Desert Cyanobacterium Capable of Far-Red Photosynthesis Under Mars-like Conditions. Life 2025, 15, 622. https://doi.org/10.3390/life15040622
Di Stefano G, Baqué M, Garland S, Lorek A, de Vera J-P, Gangi MEM, Bellucci M, Billi D. Resilience of Metabolically Active Biofilms of a Desert Cyanobacterium Capable of Far-Red Photosynthesis Under Mars-like Conditions. Life. 2025; 15(4):622. https://doi.org/10.3390/life15040622
Chicago/Turabian StyleDi Stefano, Giorgia, Mickael Baqué, Stephen Garland, Andreas Lorek, Jean-Pierre de Vera, Manuele Ettore Michel Gangi, Micol Bellucci, and Daniela Billi. 2025. "Resilience of Metabolically Active Biofilms of a Desert Cyanobacterium Capable of Far-Red Photosynthesis Under Mars-like Conditions" Life 15, no. 4: 622. https://doi.org/10.3390/life15040622
APA StyleDi Stefano, G., Baqué, M., Garland, S., Lorek, A., de Vera, J.-P., Gangi, M. E. M., Bellucci, M., & Billi, D. (2025). Resilience of Metabolically Active Biofilms of a Desert Cyanobacterium Capable of Far-Red Photosynthesis Under Mars-like Conditions. Life, 15(4), 622. https://doi.org/10.3390/life15040622







